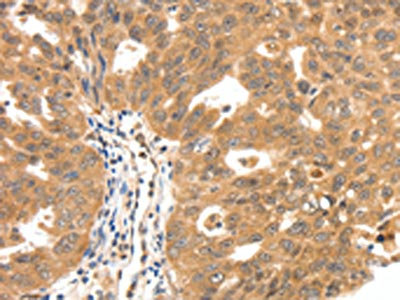

SCN5A Antibody
-
中文名稱:SCN5A兔多克隆抗體
-
貨號:CSB-PA988378
-
規格:¥1100
-
圖片:
-
The image on the left is immunohistochemistry of paraffin-embedded Human breast cancer tissue using CSB-PA988378(SCN5A Antibody) at dilution 1/30, on the right is treated with synthetic peptide. (Original magnification: ×200)
-
The image on the left is immunohistochemistry of paraffin-embedded Human ovarian cancer tissue using CSB-PA988378(SCN5A Antibody) at dilution 1/30, on the right is treated with synthetic peptide. (Original magnification: ×200)
-
-
其他:
產品詳情
-
Uniprot No.:
-
基因名:SCN5A
-
別名:Cardiac tetrodotoxin insensitive voltage dependent sodium channel alpha subunit antibody; CDCD2 antibody; CMD1E antibody; CMPD2 antibody; HB1 antibody; HB2 antibody; HBBD antibody; HH1 antibody; ICCD antibody; IVF antibody; LQT3 antibody; PFHB1 antibody; Scn5a (gene name) antibody; Scn5a antibody; SCN5A_HUMAN antibody; Sodium channel protein cardiac muscle alpha subunit antibody; Sodium channel protein cardiac muscle subunit alpha antibody; Sodium channel protein type 5 subunit alpha antibody; Sodium channel protein type V alpha subunit antibody; Sodium channel protein type V subunit alpha antibody; SSS1 antibody; VF1 antibody; Voltage gated sodium channel alpha subunit Nav1.5 antibody; Voltage-gated sodium channel subunit alpha Nav1.5 antibody
-
宿主:Rabbit
-
反應種屬:Human,Mouse,Rat
-
免疫原:Synthetic peptide of Human SCN5A
-
免疫原種屬:Homo sapiens (Human)
-
標記方式:Non-conjugated
-
抗體亞型:IgG
-
純化方式:Antigen affinity purification
-
濃度:It differs from different batches. Please contact us to confirm it.
-
保存緩沖液:-20°C, pH7.4 PBS, 0.05% NaN3, 40% Glycerol
-
產品提供形式:Liquid
-
應用范圍:ELISA,IHC
-
推薦稀釋比:
Application Recommended Dilution ELISA 1:1000-1:5000 IHC 1:25-1:100 -
Protocols:
-
儲存條件:Upon receipt, store at -20°C or -80°C. Avoid repeated freeze.
-
貨期:Basically, we can dispatch the products out in 1-3 working days after receiving your orders. Delivery time maybe differs from different purchasing way or location, please kindly consult your local distributors for specific delivery time.
-
用途:For Research Use Only. Not for use in diagnostic or therapeutic procedures.
相關產品
靶點詳情
-
功能:This protein mediates the voltage-dependent sodium ion permeability of excitable membranes. Assuming opened or closed conformations in response to the voltage difference across the membrane, the protein forms a sodium-selective channel through which Na(+) ions may pass in accordance with their electrochemical gradient. It is a tetrodotoxin-resistant Na(+) channel isoform. This channel is responsible for the initial upstroke of the action potential. Channel inactivation is regulated by intracellular calcium levels.
-
基因功能參考文獻:
- We identified a genetic variant that is associated with local anesthetic resistance in the gene encoding for Nav1.5. We also demonstrate that Nav1.5 is present in human peripheral nerves to support the plausibility that an abnormal form of the Nav1.5 protein could be responsible for the observed local anesthetic resistance. Specifically, we noted the A572D mutation in the SCN5A gene encoding for Nav1.5. PMID: 27243970
- Results demonstrate a novel pleiotropic phenotype arising from the compound SCN5A mutation, P1332L and A647D. The lethal LQT3 phenotype of P1332L was mitigated with the Brugada- associated A647D, which negated the previously reported therapeutic benefit of mexiletine. Concurrently, the A647 mutant reduced Na current sufficiently to produce a novel global cardiac conduction defect affecting the atria and ventricles. PMID: 29791480
- Study data suggest that SAR1A and SAR1B are the critical regulators of trafficking of Nav1.5. Moreover, SAR1A and SAR1B interact with MOG1, and are required for MOG1-mediated cell surface expression and function of Nav1.5. PMID: 30251687
- The failing heart has ~30% lower SCN5A levels. PMID: 28205593
- novel variants in SCN5A, KCNH2 and KCNQ1 are associated with congenital long QT syndrome in a Polish population PMID: 30244407
- The results of this study obtained in a sample from the German population do not provide evidence for an involvement of the investigated gene polymorphisms as major susceptibility factors in the pathophysiology of QTc prolongation. PMID: 29429138
- Our study expands the spectrum of SCN5A mutations and contributes to genetic counselling of families with arrhythmia. PMID: 29402340
- Here the authors show that SGK1 directly regulates NaV1.5 channel function. PMID: 28336914
- The 1795insD mutation in SCN5A reduced the beating rate of the model cell from 74 to 69 beats/min. PMID: 29473904
- Using a human-induced pluripotent stem cells -based model forSCN5A-D1275N-related sodium channelopathy, it was demonstrated that diminished sodium currents resulting from lower NaV1.5 protein levels, which is dependent on proteasomal degradation. PMID: 28637969
- We identified a double heterozygosity for pathogenic mutations in SCN5A and TRPM4 in a Brugada syndrome patient. PMID: 28494446
- This SCN5A-p.(Phe1617del) founder population with phenotypic divergence and overlap reveals long-QT syndrome-related and arousal-evoked ventricular tachyarrhythmias with a female preponderance. PMID: 28782696
- The present study revealed that Nav1.5 channels have a more abundant expression in the human brain than previously considered. It also provided further insight into the complexity and functional significance of Nav1.5 channels in human brain neurons. PMID: 29207052
- The H558R polymorphism of the SCN5A gene modifies the clinical phenotype of Brugada syndrome by modulating DNA methylation of SCN5A gene promoters. PMID: 29202755
- Idiopathic DCM (iDCM)-related SCN5A variants in the DI-S4 could predispose electrical disorders by reducing peak sodium current density. PMID: 28779003
- Full-length SCN5A was reduced in cardiac tissue from patients with hypertrophic cardiomyopathy. PMID: 28916354
- N1380del mutation of SCN5A gene leads to loss of function of sodium channel. N1380del is a pathogenetic mutation which can cause cardiac conduction defect and ventricular tachycardia. PMID: 28159958
- Nav1.5 mutations associated with long QT syndrome demostrate differential calcium sensitivity. PMID: 28734073
- These results demonstrated that readthrough-enhancing methods effectively suppressed nonsense mutations in SCN5A and restored the expression of full-length channels.channels. However, the restored channels may increase the risk of arrhythmia PMID: 28552050
- Expression of the adult and fetal isoforms of SCN5A in human induced pluripotent stem cell derived-cardiomyocytes depends on the time in culture and affects the phenotypic assessment of mutations in these cells. PMID: 28739862
- The LAT may help distinguish true LQT3-causative mutations from an otherwise noncontributory VUS. Given that lidocaine acts as a late sodium current blocker, a positive LAT may enable the early identification of a pathological accentuation of the late sodium current that could be targeted therapeutically. PMID: 28412158
- These results further support the proposition that nNav1.5 is a novel biomarker of metastatic breast cancer PMID: 28698102
- SCN5A-R1193Q is associated with cardiac conduction disturbances. It may be a genetic marker associated with ventricular arrhythmia leading to appropriate ICD shock therapy in symptomatic Brugada syndrome patients with ICD treatment. PMID: 28584071
- These sudden infant death syndrome (SIDS)-related variants caused a severely dysfunctional Nav1.5 channel, which was mainly due to trafficking defects caused by the Q1832E mutation. The decreased current density is likely to be a major contributing factor to arrhythmogenesis in Brugada syndrome and the sudden death of this SIDS victim. PMID: 28370132
- a novel missense mutation (c.1099G>C/p.R367G) in SCN5A was identified to be a possible cause of a case of familial arrhythmia. PMID: 28534967
- The late sodium current inhibitor GS-458967 exhibits anti-arrhythmic potential in human SCN5A-1795insD+/- iPSC-derived cardiomyocytes. PMID: 28430892
- A 12-lead ECG can be used to predict arrhythmias in SCN5A D1275N mutation carriers. The 12-lead electrocardiogram may reveal cardiac abnormalities before clinical symptoms occur. Electrocardiogram findings - initial QRS fragmentation, prolonged S-wave upstroke as well as supraventricular arrhythmias - were frequently encountered in all SCN5A D1257N mutation carriers. PMID: 28294644
- Novel Single Nucleotide Polymorphism at SCN5A implicate gene regulatory dysfunction in QT prolongation in African and Hispanic Americans. PMID: 27988371
- We exploited existing technologies in a novel manner to identify selective antagonists of NaV1.7. A full-deck high-throughput screen was developed for both NaV1.7 and cardiac NaV1.5 channels using a cell-based membrane potential dye FLIPR assay PMID: 26861708
- In patients with Brugada syndrome carried SCN5A mutations using cardiovascular magnetic resonance with late gadolinium enhancement may serve as early marker for evolution of a Cardiomyopathic phenotype over time. PMID: 27919765
- Brugada syndrome patients with Life-Threatening Arrhythmias underwent genetic testing, were genotype positive with SCN5A rare variants, whereas the SCN5A-negative patients remained asymptomatic. PMID: 26921764
- Variants in the core promoter region and the transcription regulatory region of SCN5A were identified in multiple arrhythmia phenotypes, consistent with the idea that altered SCN5A transcription levels modulate susceptibility to arrhythmias. PMID: 27625342
- There is a strong genotype-phenotype correlation with complete penetrance for Brugada syndrome, Long QT syndrome, or Cardiac conduction defect in the largest family harboring SCN5A-E1784K mutation described so far. Phenotype of LQTS is present during all decades of life, whereas CCD develops with increasing age. Phenotypic overlap may explain the high event rate in carriers. PMID: 27381756
- A gain-of-function missense mutation in SCN5A is associated with ventricular arrhythmias and atrial fibrillation. PMID: 28262340
- identified two novel native phosphorylation sites in the C terminus of NaV1.5 that impair FGF13-dependent regulation of channel inactivation and may contribute to CaMKIIdeltac-dependent arrhythmogenic disorders in failing hearts. PMID: 28882890
- Pathogenic variants in the SCN5A gene modify electrical excitability of sodium cannel that causes an imbalance in the currents of the different ions involved in the contraction process of the cardiomyocytes and induce ventricular remodeling and Dilated cardiomyopathy. PMID: 27736720
- Almost 2% of ARVD/C patients harbour rare SCN5A variants. For one of these variants, we demonstrated reduced sodium current, Nav1.5 and N-Cadherin clusters at junctional sites. This suggests that Nav1.5 is in a functional complex with adhesion molecules, and reveals potential non-canonical mechanisms by which Nav1.5 dysfunction causes cardiomyopathy. PMID: 28069705
- The SCN5A variants R568H and A993T can be classified as pathogenic LQTS3 causing mutations. PMID: 27287068
- Brugada syndrome patients with SCN5A mutations exhibit more conduction abnormalities on ECG. PMID: 28341781
- One common intronic variant in SCN5A is linked with risk of Ventricular Fibrillation caused by first ST-Segment Elevation Myocardial Infarction. PMID: 28085969
- Nav1.5 is hyperacetylated on K1479 in the hearts of patients with cardiomyopathy and clinical conduction disease. PMID: 28191886
- BIMU8 is a potent blocker of hERG, NaV1.5 and CaV1.2 cardiac ion channels, inducing cardiac arrhythmias. PMID: 28552773
- It might be important to suspect the coexistence of DCM and LQT3 (which is rare according to previous articles) in cases with this novel SCN5A missense mutation PMID: 28011106
- Mutational analysis across all 29 exons in SCN5A of the proband and first-degree relatives of the family revealed that the proband inherited a compound heterozygote mutation in SCN5A, specifically p.A226V and p.R1629X from each parent. The study is the first to report a SCN5A compound heterozygote in a Singaporean Chinese family. PMID: 25829473
- Clinically relevant cardiotoxicity of domperidone and metoclopramide corresponds to a rather potent and local anesthetic-like inhibition of cardiac Na channels including Nav1.5. PMID: 27861438
- The H558R polymorphism in the SCN5A gene has been associated with the LQT3 syndrome and possibly can influence repolarization and depolarization of cardiac muscle cells. PMID: 26109178
- There are 12 loci possibly associated with BrS, the most common of which is the sodium voltage-gated channel alpha subunit 5 (SCN5A), resulting in hNav1.5 loss of function leading to type 1 BrS. PMID: 27810048
- Ranolazine blocks INaL in experimental models of LQT3 harboring the SCN5A-D1790G mutation and shortened the QT interval of LQT3 patients. PMID: 27733495
- We conclude that Gentamycin and PTC124 are unlikely to present an effective treatment for patients carrying the loss-of-function SCN5A gene mutations examined in this study. PMID: 27784737
- rs3922844 was associated with QRS duration and SCN5A expression, two novel QRS loci were identified using transethnic meta-analysis, and a significant proportion of QRS-SNP associations discovered in populations of European descent were transferable to African Americans when adequate power was achieved PMID: 27577874
顯示更多
收起更多
-
相關疾病:Progressive familial heart block 1A (PFHB1A); Long QT syndrome 3 (LQT3); Brugada syndrome 1 (BRGDA1); Sick sinus syndrome 1 (SSS1); Familial paroxysmal ventricular fibrillation 1 (VF1); Sudden infant death syndrome (SIDS); Atrial standstill 1 (ATRST1); Cardiomyopathy, dilated 1E (CMD1E); Atrial fibrillation, familial, 10 (ATFB10)
-
亞細胞定位:Cell membrane; Multi-pass membrane protein. Cytoplasm, perinuclear region. Cell membrane, sarcolemma, T-tubule.
-
蛋白家族:Sodium channel (TC 1.A.1.10) family, Nav1.5/SCN5A subfamily
-
組織特異性:Found in jejunal circular smooth muscle cells (at protein level). Expressed in human atrial and ventricular cardiac muscle but not in adult skeletal muscle, brain, myometrium, liver, or spleen. Isoform 4 is expressed in brain.
-
數據庫鏈接:
Most popular with customers
-
-
YWHAB Recombinant Monoclonal Antibody
Applications: ELISA, WB, IHC, IF, FC
Species Reactivity: Human, Mouse, Rat
-
Phospho-YAP1 (S127) Recombinant Monoclonal Antibody
Applications: ELISA, WB, IHC
Species Reactivity: Human
-
-
-
-
-